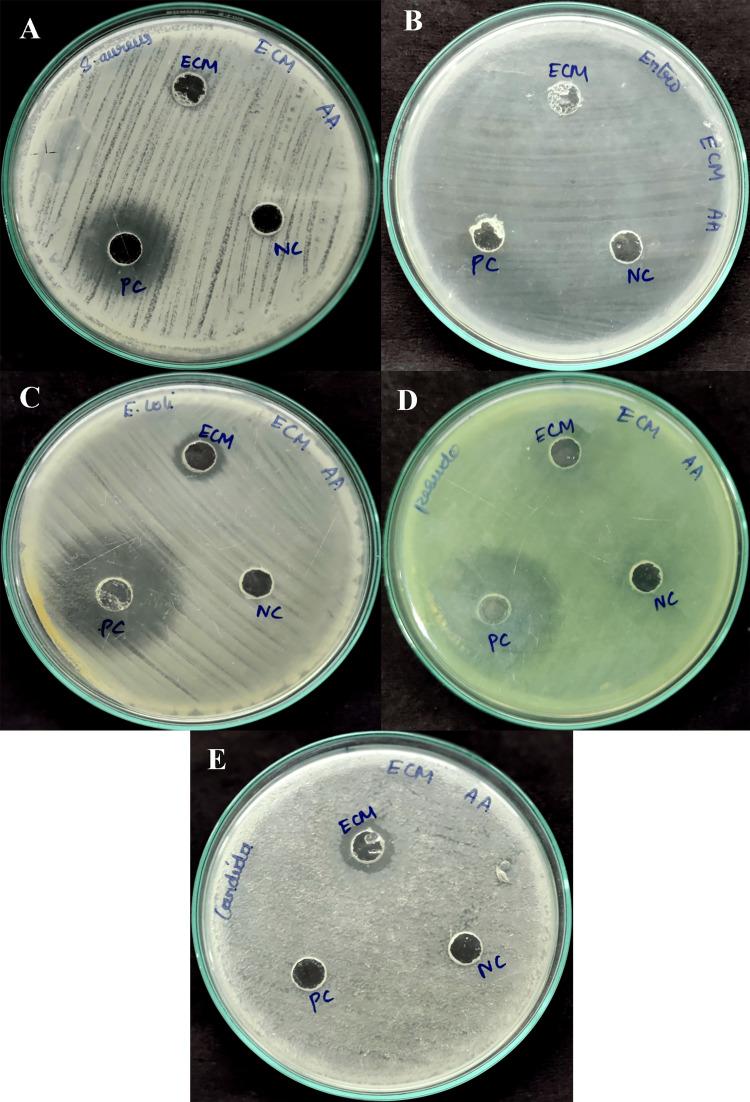
https://cdn.ncbi.nlm.nih.gov/pmc/blobs/1977/11414998/9f0b240eecb2/cureus-0016-00000067246-i03.jpg

嗜盐芽孢杆菌属的次生代谢产物:抗菌和抗氧化活性、生物相容性及气相色谱-质谱联用(GC-MS)分析
Secondary Metabolites of Halobacillus sp.: Antimicrobial and Antioxidant Activity, Biological Compatibility, and Gas Chromatography-Mass Spectrometry (GC-MS) Analysis.
作者信息
Saleem Aayisha Aathila, Balakrishnan Gayathri, Nandhagopal Manivannan
机构信息
Biocontrol and Microbial Products Lab, Department of Microbiology, Saveetha Medical College and Hospitals, Saveetha Institute of Medical and Technical Sciences, Saveetha University, Chennai, IND.
出版信息
Cureus. 2024 Aug 19;16(8):e67246. doi: 10.7759/cureus.67246. eCollection 2024 Aug.
Background The rise of infectious diseases and the emergence of resistant pathogens pose significant challenges to human health. In response to this global threat, researchers are exploring novel sources of bioactive compounds for effective antimicrobial therapies. One avenue of investigation is the study of halophilic bacteria and their secondary metabolites. These bacteria thrive under extreme conditions and produce valuable bioactive metabolites, which have the potential for therapeutic applications. Methods In this study, the potent bacterial cultures obtained from the Payanur salt pan, Tamil Nadu, were analyzed for the antimicrobial activity of their metabolites. The secondary metabolites were obtained from the halophilic bacteria by culturing the bacteria in 8% NaCl. The resultant secondary metabolites produced were extracted using ethyl acetate and their antimicrobial property was studied using the well diffusion method. The minimum inhibitory concentration (MIC) of these metabolites against five clinical pathogens, namely, and was determined. Their antioxidant property was studied using the DPPH (2,2-diphenyl-1-picrylhydrazyl) method and biological compatibility was determined by hemolytic assay of the secondary metabolites. Results The potent halophilic bacteria isolated from salt pan bacteria were phenotypically and genotypically identified as sp The secondary metabolites extracted from these bacteria yielded 110 mg of crude metabolites. The antimicrobial activity of crude metabolites shows a moderate zone of inhibition of 14 mm for , 13 mm for and and 11 mm for . The minimum inhibitory concentration was 128 µg/mL for , and which was found to be the best growth inhibition concentration. The DPPH scavenging activity shows a higher activity till the concentration of 64 µg/mL. The hemolytic activity of 25% is obtained at 128 µg/mL and below 64 µg/mL, there is no hemolytic activity. The gas chromatography-mass spectrometry (GC-MS) analysis of the secondary metabolites shows the presence of 17 compounds. Among them, there were four major compounds: (i) cyclo(L-prolyl-L-valine) (probability of 95.63%), (ii) pyrrolo[1,2-a]pyrazine- 1,4-dione,hexahydro-3-(2-methylpropl) (probability of 94.45%), (iii) 2,5-piperazinedione,3,6-bis(2-methylpropyl) (probability of 71.94%) and (iv) pyrrolo[1,2-a]pyrazine-1,4-dione,hexahydro-3-(phenylmethyl) (probability of 88.01%). Conclusion In conclusion, the isolated bacterium is confirmed to be sp.and the secondary metabolites produced by this bacterium could be the potential source for the development of novel antimicrobial and antioxidant compounds that are highly biologically compatible. Further research may help to develop novel compounds in the pharmaceutical industry.
背景 传染病的增加和耐药病原体的出现对人类健康构成了重大挑战。为应对这一全球威胁,研究人员正在探索用于有效抗菌治疗的生物活性化合物的新来源。其中一条研究途径是对嗜盐细菌及其次生代谢产物进行研究。这些细菌在极端条件下生长旺盛,并产生有价值的生物活性代谢产物,具有治疗应用潜力。方法 在本研究中,对从泰米尔纳德邦帕亚努尔盐田获得的强效细菌培养物的代谢产物进行抗菌活性分析。次生代谢产物是通过将嗜盐细菌在8%氯化钠中培养而获得的。使用乙酸乙酯提取产生的次生代谢产物,并采用打孔扩散法研究其抗菌性能。测定了这些代谢产物对五种临床病原体的最低抑菌浓度(MIC)。使用DPPH(2,2-二苯基-1-苦基肼)法研究其抗氧化性能,并通过次生代谢产物的溶血试验确定其生物相容性。结果 从盐田细菌中分离出的强效嗜盐细菌在表型和基因型上被鉴定为 种。从这些细菌中提取的次生代谢产物产生了110毫克粗代谢产物。粗代谢产物的抗菌活性显示,对 有14毫米的中度抑菌圈,对 和 有13毫米,对 有11毫米。对 、 和 的最低抑菌浓度为128微克/毫升,这被认为是最佳生长抑制浓度。DPPH清除活性在浓度为64微克/毫升之前显示出较高活性。在128微克/毫升时获得25%的溶血活性,在64微克/毫升以下无溶血活性。次生代谢产物的气相色谱-质谱(GC-MS)分析显示存在17种化合物。其中有四种主要化合物:(i)环(L-脯氨酰-L-缬氨酸)(概率为95.63%),(ii)吡咯并[1,2-a]吡嗪-1,4-二酮,六氢-3-(2-甲基丙基)(概率为94.45%),(iii)2,5-哌嗪二酮,3,6-双(2-甲基丙基)(概率为71.94%)和(iv)吡咯并[1,2-a]吡嗪-1,4-二酮,六氢-3-(苯甲基)(概率为88.01%)。结论 总之,已确认分离出的细菌为 种,该细菌产生的次生代谢产物可能是开发具有高度生物相容性的新型抗菌和抗氧化化合物的潜在来源。进一步的研究可能有助于在制药行业开发新型化合物。